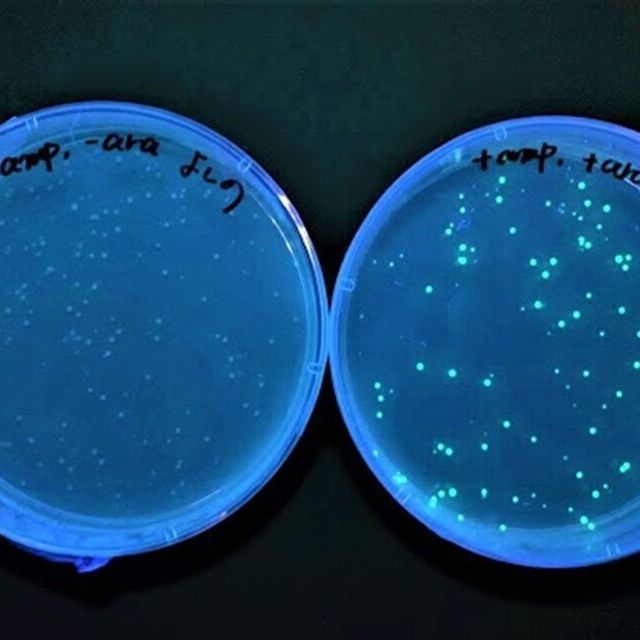
専門学校　東京テクニカルカレッジ 【バイオテクノロジー科】光る大腸菌！？DNA実験に挑戦1

専門学校 東京テクニカルカレッジのオープンキャンパス
オープンキャンパス
【バイオテクノロジー科】光る大腸菌!?DNA実験に挑戦

-
開催日時
-
-
2026年
7月
18日
(土)
10:00~12:30
-
14:00~16:30
-
対象学部・学科・コース
-
バイオテクノロジー科
内容
■内容
光る大腸菌?!DNA実験に挑戦してみよう!
大学受験も考えている人におすすめ!
■タイムスケジュール
<amの部>
9:30~ 受付
10:00~ オープニング(全体)
10:10~ 学科説明・体験メニュー
12:00~ 個別相談
12:30 終了
<pmの部>
13:30~ 受付
14:00~ オープニング(全体)
14:10~ 学科説明・体験メニュー
16:00~ 個別相談
16:30 終了
*amの部、pmの部どちらも同内容です。ご自身の都合に合わせて参加する時間を選んでね!
\学科説明・個別相談も実施/
楽しい体験メニューだけでなく、個別での相談や学科説明の時間もあります!入学相談室のスタッフが優しく丁寧におこたえします♪
\保護者説明会も同時開催/
お子さまが体験中、保護者の方向けに説明会を実施!学費についてや手続き方法についてなど、不安なことやご質問があればぜひ当日ご質問ください!
このオープンキャンパスに参加しよう!
※イベント情報は各学校から入稿いただいた内容、または各学校が公表した内容を掲載していますので、詳細は各学校にお問い合わせください。
専門学校 東京テクニカルカレッジのオープンキャンパス
ピックアップ
 専門学校 東京テクニカルカレッジ バイオテクノロジー科
専門学校 東京テクニカルカレッジ バイオテクノロジー科
遺伝子組み換えや生物の細胞観察など、バイオ実験をしてみよう!
DNAの抽出や、顕微鏡で微生物や細胞などミクロの世界を観察しよう!実験をとおしてバイオ技術を体験!
専門学校 東京テクニカルカレッジ
-
-
-
-
-
-
-
-
-
-
-
-
-
 専門学校 東京テクニカルカレッジ バイオテクノロジー科
専門学校 東京テクニカルカレッジ バイオテクノロジー科
遺伝子組み換えや生物の細胞観察など、バイオ実験をしてみよう!
DNAの抽出や、顕微鏡で微生物や細胞などミクロの世界を観察しよう!実験をとおしてバイオ技術を体験!
専門学校 東京テクニカルカレッジ
-
-
-
-
-
-
-
-
-
-
-
-
-
 専門学校 東京テクニカルカレッジ バイオテクノロジー科
専門学校 東京テクニカルカレッジ バイオテクノロジー科
遺伝子組み換えや生物の細胞観察など、バイオ実験をしてみよう!
DNAの抽出や、顕微鏡で微生物や細胞などミクロの世界を観察しよう!実験をとおしてバイオ技術を体験!
専門学校 東京テクニカルカレッジ
-
-
-
-
-
-
-
-
-
-
-
-
-
他のイベント
-
-
-
-
-
-
-
-
-
-
-
-
- 開催日時
-
-
2026年7月18日(土)10:00~12:30
-
14:00~16:30
-
- 対象学部・学科・コース
- バイオテクノロジー科
内容
■内容
光る大腸菌?!DNA実験に挑戦してみよう!
大学受験も考えている人におすすめ!
■タイムスケジュール
<amの部>
9:30~ 受付
10:00~ オープニング(全体)
10:10~ 学科説明・体験メニュー
12:00~ 個別相談
12:30 終了
<pmの部>
13:30~ 受付
14:00~ オープニング(全体)
14:10~ 学科説明・体験メニュー
16:00~ 個別相談
16:30 終了
*amの部、pmの部どちらも同内容です。ご自身の都合に合わせて参加する時間を選んでね!
\学科説明・個別相談も実施/
楽しい体験メニューだけでなく、個別での相談や学科説明の時間もあります!入学相談室のスタッフが優しく丁寧におこたえします♪
\保護者説明会も同時開催/
お子さまが体験中、保護者の方向けに説明会を実施!学費についてや手続き方法についてなど、不安なことやご質問があればぜひ当日ご質問ください!
光る大腸菌?!DNA実験に挑戦してみよう!
大学受験も考えている人におすすめ!
■タイムスケジュール
<amの部>
9:30~ 受付
10:00~ オープニング(全体)
10:10~ 学科説明・体験メニュー
12:00~ 個別相談
12:30 終了
<pmの部>
13:30~ 受付
14:00~ オープニング(全体)
14:10~ 学科説明・体験メニュー
16:00~ 個別相談
16:30 終了
*amの部、pmの部どちらも同内容です。ご自身の都合に合わせて参加する時間を選んでね!
\学科説明・個別相談も実施/
楽しい体験メニューだけでなく、個別での相談や学科説明の時間もあります!入学相談室のスタッフが優しく丁寧におこたえします♪
\保護者説明会も同時開催/
お子さまが体験中、保護者の方向けに説明会を実施!学費についてや手続き方法についてなど、不安なことやご質問があればぜひ当日ご質問ください!
ピックアップ

専門学校 東京テクニカルカレッジ バイオテクノロジー科
遺伝子組み換えや生物の細胞観察など、バイオ実験をしてみよう!
DNAの抽出や、顕微鏡で微生物や細胞などミクロの世界を観察しよう!実験をとおしてバイオ技術を体験!
専門学校 東京テクニカルカレッジ

専門学校 東京テクニカルカレッジ バイオテクノロジー科
遺伝子組み換えや生物の細胞観察など、バイオ実験をしてみよう!
DNAの抽出や、顕微鏡で微生物や細胞などミクロの世界を観察しよう!実験をとおしてバイオ技術を体験!
専門学校 東京テクニカルカレッジ

専門学校 東京テクニカルカレッジ バイオテクノロジー科
遺伝子組み換えや生物の細胞観察など、バイオ実験をしてみよう!
DNAの抽出や、顕微鏡で微生物や細胞などミクロの世界を観察しよう!実験をとおしてバイオ技術を体験!
専門学校 東京テクニカルカレッジ











